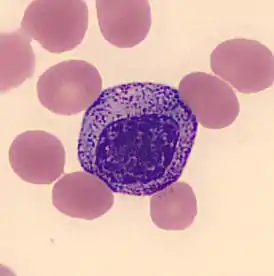

Миелоцит
Миелоцит — это молодая клетка гранулоцитарного ростка, в норме находящаяся в костном мозге, но не в периферической крови.
| Миелоцит | |
|---|---|
| |
| Каталоги | |



Морфология
При обычной окраске гематоксилин — эозином цитоплазма миелоцита резко базофильна. Её относительно больше, чем в миелобластах или в промиелоцитах, несмотря на то, что миелоцит — менее крупная клетка, чем миелобласт или промиелоцит.
В более зрелых формах миелоцитов наблюдаются обильные специфические цитоплазматические гранулы. Нейтрофильные и эозинофильные гранулы положительны на миелопероксидазу, в то время как базофильные гранулы — отрицательны.
Ядерный хроматин выглядит грубее, чем наблюдающийся у миелоцитов, но относительно бледно окрашен и не имеет чётко выраженной мембраны.
Ядро миелоцита довольно правильных округлых чертаний (не имеет почкообразных «вмятин») и выглядит «затерявшимся» среди многочисленных цитоплазматических гранул. Если ядро клетки имеет почкообразную «вмятину» или вдавленность, то это, скорее всего, уже не миелоцит, а следующая стадия развития — метамиелоцит.
Созревание
Миелоциты развиваются из миелобластов через стадию промиелоцита. В свою очередь, следующей стадией дифференцировки после миелоцита является метамиелоцит.
Метод измерения количества
Существует международный консенсус специалистов по методике подсчёта бластных клеток разных степеней созревания, от M0, M1 и выше.
Дополнительные изображения
Гемопоэз у человека (схематично)
Примечания
- Myelocyte // Foundational Model of Anatomy